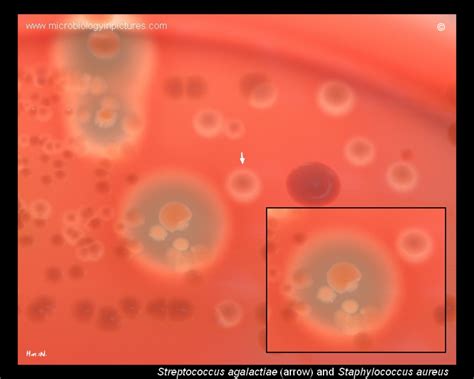
streptococcus agalactiae  staphylococcus aureus comparison growth

Jika kamu sedang mencari Agalactiae Blood Agar, maka anda berada di halaman yang tepat. Kami menyediakan aneka Agalactiae Blood Agar yang bisa anda pesan online. Silakan hubungi kami via +6282245078486, jangan lupa sertakan juka gambar yang diinginkan.
Kami mengirim paket Agalactiae Blood Agar melalui berbagai ekspedisi, misalnya JNE, JNT, POS, dll. Kami juga menerima pembayaran via BCA/Mandiri/dll. Pengiriman biasanya tidak sampai seminggu sudah sampai dan kami sertakan pula nomor resi yang bisa digunakan untuk tracking barang secara online.

Tidak hanya Agalactiae Blood Agar, anda juga bisa melihat gambar lain seperti
Bacillus Subtilis,
Gamma Hemolysis,
Enterococcus Faecalis,
Bacillus Anthracis,
Streptococcus Pyogenes,
Yersinia Enterocolitica,
Staph Aureus,
Alpha Hemolysis,
Proteus Mirabilis,
Clostridium Botulinum,
Medical Technologist,
Haemophilus Influenzae,
Vibrio Cholerae,
Fusobacterium Nucleatum,
Greek Yogurt,
Gram Positive or Negative,
Gram Neg Bacilli,
Plate Preparation,
Blood Agar Plate,
Blood Agar Media,
Blood Agar Hemolysis,
Proteus Blood Agar,
MacConkey Agar Plate,
Columbia Blood Agar,
Yersinia On Blood Agar,
Salmonella On Blood Agar,
EMB Agar,
Aeromonas On Blood Agar,
and Plate Count Agar.
Berbagai Contoh Agalactiae Blood Agar
Berikut kami sertakan berbagai contoh gambar untuk Agalactiae Blood Agar, silakan save gambar di bawah dengan klik tombol pesan, anda akan kami arahkan pemesanan via WA ke +6282245078486.
 800×640
800×640
streptococcus agalactiae growing petri dish cap blood beta
Order Sekarang
 783×581
783×581
bacterial colonies streptococcus agalactiae blood
Order Sekarang
 1125×1600
1125×1600
streptococcus group streptococcus agalactiae blood stock photo
Order Sekarang
 800×640
800×640
streptococcus agalactiae staphylococcus aureus comparison growth
Order Sekarang
 735×712
735×712
streptococcus agalactiae en sangre streptococcus agalactiae
Order Sekarang
 1600×1290
1600×1290
streptococcus agalactiae hemolysis stock image image
Order Sekarang
 1152×1536
1152×1536
streptococcus agalactiae sheep blood streptococcus agalactiae
Order Sekarang
 850×860
850×860
hemolytic colonies streptococcus agalactiae blood
Order Sekarang
 768×782
768×782
streptococcus agalactiae overview microbe notes
Order Sekarang
 1280×720
1280×720
streptococcus agalactiae introduction morphology pathogenicity
Order Sekarang
 609×612
609×612
streptococcus agalactiae stock pictures royalty
Order Sekarang
650×520
650×520
group streptococcus colonies streptococcus agalactiae blood
Order Sekarang
 650×520
650×520
beta hemolytic streptococcus group growing blood
Order Sekarang
 713×694
713×694
blood showing beta hemolytic colony introduction organism
Order Sekarang
 595×594
595×594
streptococcus agalactiae gbs properties pathogenesis lab diagnosis
Order Sekarang
 650×520
650×520
streptococcus agalactiae photograph colonies hemolysis growing
Order Sekarang
 1024×576
1024×576
blood introduction composition principle preparation
Order Sekarang
 650×520
650×520
sagalactiae colonies morphology hemolysis streptococcus
Order Sekarang
 650×520
650×520
streptococcus agalactiae mixed culture nonhemolytic colonies
Order Sekarang
 1500×1125
1500×1125
streptococcus agalactiae group streptococci microbiology
Order Sekarang
 650×520
650×520
colonies gbs streptococcus agalactiae blood incomplete
Order Sekarang
 650×520
650×520
gbs group beta hemolytic streptococcus blood streptococcus
Order Sekarang
 650×520
650×520
group streptococcusgbs sagalactiae beta hemolytic group
Order Sekarang
 1500×1362
1500×1362
stokovaya fotografiya streptococcus pyogenes streptococcus
Order Sekarang
 1020×439
1020×439
blood preparation composition application limitation
Order Sekarang
Temukan solusi terbaik untuk kenyamanan ruang Anda dengan Agalactiae Blood Agar! Produk peredam suara dan panas ini menawarkan performa maksimal dengan harga yang terjangkau. Dapatkan kualitas unggul tanpa menguras kantong, dan nikmati suasana tenang serta sejuk di setiap sudut rumah atau kantor Anda. Pilih Agalactiae Blood Agar – pilihan cerdas untuk investasi jangka panjang!
Maaf, tidak ada yang cocok dengan kriteria yang Anda cari.
Apa yang ingin Anda lakukan?
« kembali ke Beranda atau gunakan kotak pencarian dibawah ini untuk mulai penelusuran baru.










